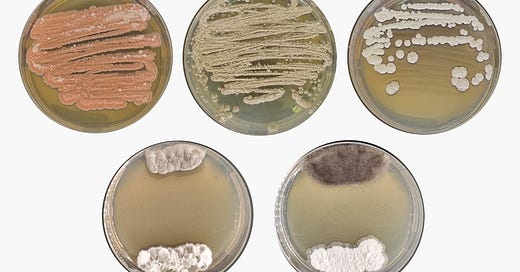

Microrganismos da Amazônia revelam potencial agrícola e metabólitos inéditos
Pesquisa realizada na Esalq identifica microrganismos amazônicos com potencial aplicação como bioinsumos, além de produzirem produtos naturais nunca antes reportados
"Nosso trabalho mostra como microrganismos da floresta amazônica podem contribuir tanto para a redução do uso de insumos sintéticos no campo quanto para a descoberta de novos compostos com potencial farmacológico", afirma a pesquisadora.
Um estudo desenvolvido no Programa de Pós-Graduação em Microbiologia Agrícola da Escola Superior de Agricultura Luiz de Queiroz (Esalq/USP) revelou o potencial de microrganismos isolados da floresta amazônica na promoção do crescimento de plantas, no controle de doenças agrícolas e na descoberta de compostos bioativos inéditos. A pesquisa explorou actinobactérias, um grupo de bactérias conhecido pela rica produção de metabólitos com aplicações agrícolas e farmacêuticas.
De autoria da bióloga Naydja Moralles Maimone, a pesquisa foi realizada no Laboratório de Microbiologia Agrícola e Química de Produtos Naturais, sob orientação da professora Simone Lira. O projeto reuniu pesquisadores da própria Esalq, da USP São Carlos e da Simon Fraser University (Canadá), com apoio da CAPES e da Fapesp.
“As actinobactérias estudadas foram isoladas de solos amazônicos e estavam armazenadas no Laboratório de Genética de Microrganismos “Prof. João Lúcio de Azevedo”, da Esalq. Destacamos o caráter interdisciplinar deste estudo, que englobou diferentes áreas da microbiologia, genética e química orgânica”, conta a pesquisadora.
A pesquisa utilizou técnicas avançadas de metabolômica e genômica, revelando como o microbioma amazônico é uma fonte ainda pouco explorada de inovação para uma agricultura mais sustentável e para a descoberta de novas moléculas bioativas.
Duas das linhagens avaliadas se destacaram. A Streptomyces sp. AM25 demonstrou forte potencial como bioinsumo agrícola, promovendo o crescimento de plantas de milho e inibindo fungos que atacam culturas como soja, milho e tomate. Já a Streptantibioticus sp. AM24 surpreendeu por produzir compostos inéditos, como duas novas acidifilamidas - tripeptídeos com estruturas químicas não usuais, uma delas contendo uma modificação jamais descrita anteriormente em metabólitos originados de microrganismos.
"Nosso trabalho mostra como microrganismos da floresta amazônica podem contribuir tanto para a redução do uso de insumos sintéticos no campo quanto para a descoberta de novos compostos com potencial farmacológico", afirma a pesquisadora.
Tese Destaque é uma parceria entre a Comissão de Pós-Graduação e a Divisão de Comunicação da Esalq. Clique aqui e acesse a coleção completa.
FOTO: Actinobactérias, prolíficas produtoras de metabólitos especializados (crédito: Juan Lopes Teixeira)